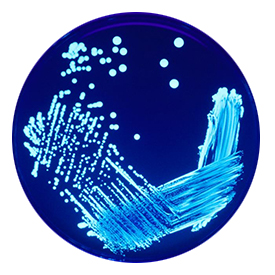

988 271 861
laboratorio@akunatura.com
698 108 635
comerciales@akunatura.com
988 271 861
laboratorio@akunatura.com
698 108 635
comerciales@akunatura.com
En Akunatura, nos comprometemos a ofrecer servicios de alta calidad para el cuidado de su salud. Por eso, hemos incorporado a nuestra sección clínica el servicio de pruebas PCR, el método más eficaz y reconocido para la detección del virus SARS-CoV-2, causante de la COVID-19.
La prueba PCR (Reacción en Cadena de la Polimerasa) es una técnica de diagnóstico molecular que permite detectar el material genético del virus con un alto nivel de precisión. A diferencia de otros métodos, la PCR es capaz de identificar incluso cantidades mínimas del virus, lo que la convierte en la opción más confiable y sensible para el diagnóstico temprano y la confirmación de casos.
Nuestro laboratorio está equipado con tecnología de última generación y un equipo de profesionales expertos que garantizan resultados precisos y rápidos, cumpliendo con los protocolos más estrictos de bioseguridad para la seguridad de todos.
Confíe en Akunatura para obtener un diagnóstico seguro y profesional.
Akunatura es un laboratorio de análisis de aguas acreditado según la norma ISO 9001. Estamos habilitados para la gestión de resultados en la plataforma SINAC para aguas de consumo humano, asi como en la plataforma SILOE para aguas de piscinas. Contamos además con la acreditación ENAC para la determinación de diversos parámetros.
Contamos con capacidad para el análisis de:
Akunatura cuenta con la capacidad para:
Necesario para el cumplimiento del Real Decreto 865/2003 de 4 de Julio, por el que se establecen los criterios higiénico-sanitarios para la prevención y control de la legionelosis.
Uno de los objetivos de Akunatura como laboratorios es poner a disposición de nuestros clientes una solución completa. Dentro de la industria alimentaria cubriendo las siguientes necesidades:
Según la legislación vigente todas las empresas del sector alimentario están obligadas a contar con el sistema APPCC. Este sistema nos permite adelantarnos a los problemas, es un sistema de prevención, y si aparecen problemas también se especifica qué debemos hacer. Su objetivo es obtener alimentos seguros para la salud del consumidor. Akunatura cuenta con técnicos para la correcta elaboración de toda la documentación necesaria, la formación y la implantación de su sistema APPCC.

Control microbiológico de los productos cosméticos en todas las fases de la producción. Akunatura tiene la capacidad de supervisión y seguimiento de productos cosméticos con análisis microbiológicos y físico-químicos, así como para la elaboración de la documentación pertinente, necesaria para poner el producto en el mercado.
